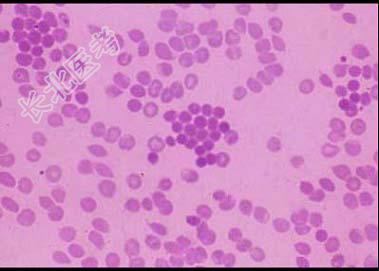

试题详情
- 单项选择题某家族性遗传病患者血涂片如图,红细胞渗透脆性增加, 下述哪项不符合其病情。 ( )
A、脾肿大
B、红细胞在脾窦被破坏
C、血红蛋白电泳出现异常区带
D、尿胆原阳性
E、网织红细胞明显增高
关注下方微信公众号,搜题查看答案

热门试题
- 下列选项不属于临床血液学研究内容的是
- 红细胞在体内能维持120天左右的寿命,主
- 下述各项,有助于鉴别急性粒细胞白血病和急
- 下列哪项不符合毛细血管的生理 (
- 在真性红细胞增多症的病人一般不会有A、脾
- 多发性骨髓瘤患者尿中主要出现( )A
- 新生儿同种免疫性溶血性贫血的临床特点下列
- 弥散性血管内凝血的基本病变是A、微血管血
- 红细胞G6PD缺乏症诊断的试验不包括A、
- 血红素合成场所为 ( )A、肝细
- 下列对造血多能干细胞发生作用的造血生长因
- 被称之为粒细胞酯酶的是 ( )A
- 国际血液学标准化委员会推荐用于止凝血试验
- 血小板黏附率降低见于下列哪一种疾病A、心
- FAB分类法诊断急性淋巴细胞白血病L1型
- 下列说法错误的是A、在使用链激酶、尿激酶
- 肝病时,测定结果减低的纤溶系统指标包括(
- 下列属于造血功能障碍所致的贫血是 (
- 某出血性疾病患者,实验室检查结果是: P
- 血沉减慢见于以下哪种疾病A、真性红细胞增